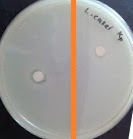

INTODUCTION
Certain groups of bacteria can produce antimicrobial substances with the capacity to inhibit the growth of pathogenic and spoilage microorganisms. Organic acid, hydrogen peroxide, diacetyl and bacteriocins are included among these antimicrobial compounds. Interest in naturally produced antimicrobial agents such as bacteriocins, is on the rise, since nowadays consumers demand natural and minimally processed food.
Bacteriocins comprise a large and diverse group of ribosomally synthesized antimicrobial protein or peptides. Although bacteriocins can be found in numerous Gram-positive and Gram-negative bacteria, those produced by lactic acid bacteria (LAB) have received special attention in recent years due to their potential application in the food industry as natural biopreservatives. Different classes of LAB bacteriocins have been identified on the basis of biochemical and genetic characterization. These bacteriocins have been reported to inhibit the growth of Listeria monocytogenes, Staphylococcus aures, Enterococcus faecalis and Clostridium tyrobutyricum.
Two methods can be used. First determination of bacterion activity using agar diffusion test and using optical density. Part 1: Determination of bacterion activity via agar diffusion test
The agar diffusion test, or the Kirby-Bauer disk-diffusion method, is a means of measuring the effect of an antimicrobial agent against bacteria grown in culture.
The bacteria in question is swabbed uniformly across a culture plate. A filter-paper disk, impregnated with the compound to be tested, is then placed on the surface of the agar. The compound diffuses from the filter paper into the agar. The concentration of the compound will be highest next to the disk, and will decrease as distance from the disk increases. If the compound is effective against bacteria at a certain concentration, no colonies will grow where the concentration in the agar is greater than or equal to the effective concentration. This is the zone of inhibition. Thus, the size of the zone of inhibition is a measure of the compound's effectiveness: the larger the clear area around the filter disk, the more effective the compound. In microbiology, minimum inhibitory concentration (MIC) is the lowest concentration of an antimicrobial that will inhibit the visible growth of a microorganism after overnight incubation. Minimum inhibitory concentrations are important in diagnostic laboratories to confirm resistance of microorganisms to an antimicrobial agent and also to monitor the activity of new antimicrobial agents. A lower MIC is an indication of a better antimicrobial agent. A MIC is generally regarded as the most basic laboratory measurement of the activity of an antimicrobial agent against an organism.
Part 2: Determination of bacterion activity via optical density.
A spectrophotometer is an optical device that can determine the concentration of a compound or particles in a solution or suspension.
Light of a pre-selected wavelength is shone through a chamber that houses the sample. The sample particles, bacteria for example, will absorb some of the light. The amount of light that is absorbed increases with increasing numbers of bacteria in a predictable way. The relationship between absorbance and the number of absorbing sample molecules is expressed mathematically as the Beer-Lambert Law.The percent of light that has been absorbed can be determined and, by comparing this absorption to a graph of the absorption of known numbers of bacteria, the concentration of bacteria in the suspension can be computed. In a microbiology laboratory, such measurements are routinely used in bacterial growth studies, to determine the number of bacteria growing in a culture at certain times based on the absorbance of the suspension. A standard curve can be constructed that relates the various measured optical densities to the resulting number of living bacteria, as determined by the number of bacteria from a defined portion of the suspensions that grows on agar medium.
OBJECTIVE
OBJECTIVE
To determine the antimicrobial effects of extracellular extracts of selected LAB strains
RESULTS
PART 1: Determination of bacterion activity via agar diffusion test
Calculation
DATA
SHEET
PART
1 : DETERMINATION OF BACTERIOCIN ACTIVITY VIA AGAR DIFFUSION TEST
STRAINS OF LAB
|
STRAINS OF SPOILAGE /
PATHOGENIC BACTERIA
|
INHIBITION ZONE (cm)
|
L.plantarum
|
S.aureus
|
0.60
|
K.pneumoniae
|
1.15
|
|
P.aeruginosa
|
-
|
|
L.brevis
|
S.aureus
|
-
|
K.pneumoniae
|
0.70
|
|
P.aeruginosa
|
0.80
|
|
L.casei
|
S.aureus
|
-
|
K.pneumoniae
|
1.00
|
|
P.aeruginosa
|
0.65
|
L.plantarum
Kp
Sa
Pa
L.brevis
Kp
Sa
Pa
L.casei
Kp
Sa
Pa
Part 2: Determination of bacterion activity via optical density.
Serial dilution of extracellular extract
Strain of lab : L.plantarum
DILUTION
|
OD600 of spoilage / pathogenic
bacteria
|
||
STRAIN 1: P.aeruginosa
|
STRAIN 2: S.aureus
|
STRAIN 3: K.pneumoniae
|
|
0x
|
-
|
-
|
-
|
2x
|
1.025
|
0.787
|
0.871
|
10x
|
0.733
|
0.772
|
0.595
|
50x
|
0.755
|
0.560
|
0.506
|
100x
|
0.260
|
0.321
|
0.237
|
EQUATION
|
Y= -0.2273X + 1.4888
|
Y= -0.161X + 1.1735
|
Y= -0.1991X + 1.2491
|
POSITIVE CONTROL(Z)
|
0.432
|
0.270
|
0.829
|
50% of POSITIVE CONTROL (Z/2)
|
0.216
|
0.135
|
0.4215
|
AU/mL
|
5.5996
|
6.4503
|
4.1919
|
STRAIN 1: P.aeruginosa
STRAIN 2: S.aureus
STRAIN 3: K.pneumoniae
PART 1: Determination of bacterion activity via agar diffusion test
In this experiment, we need to determine the antimicrobial effects of extracellular extracts of selected LAB strains. An antimicrobial is a substance that kills or inhibits the growth of microorganisms such as bacteria, fungi, or protozoans. Antimicrobial drugs either kill microbes (microbiocidal) or prevent the growth of microbes (microbiostatic).The principle of this method is dependent upon the inhibition of reproduction of a microorganism on the surface of a solid medium by an antimicrobial agent which diffuses into the medium from a filter paper disc. Thus, for an organism which is truly sensitive (susceptible) to an antimicrobial agent The principle of this method is dependent upon the inhibition of reproduction of a microorganism on the surface of a solid medium by an antimicrobial agent which diffuses into the medium from a filter paper disc. Thus, for an organism which is truly sensitive (susceptible) to an antimicrobial agent. Accurate measurement of zone diameter is necessary to properly interpret this test.
Lactobacilli is the inhibitor that inhibit most of all the microbial activity of Gram positive bacteria compare to the Gram negative bacteria. In this experiment, S.aureus is the type of Gram positive bacteria, K.pneumoniae and P.aeruginosa the type of Gram negative. Based on the result obtain, L.plantarum inhibit the activity of S.aureus and the inhibition zone is 0.6cm. There were an error occured during the procedure because S.aureus should gave the highest result compared to the two patogen. The depth of the paper disk are not deep enough and thus gave the error in our result.
Part 2: Determination of bacterion activity via optical density.
In part 2, we need to determine the bacterial activity via optical density(spectrophotometer). Upon the incubation process, the measurement of the optical density of the spoilage or pathogenic bacteria is taken at 600nm. From the experiment, the arbitrary unit(AU/mL) or the dilution factor of the extracellular extract that inhibit 50% of the spoilage is determined. Several dilution has been done and the 2x dilution gaves the highest reading for the three of the species. After the calculation, it have been determined that S.aureus gave the higest value compare the two. The gram positive gave the higher value compare to the gram negative.
CONCLUSION
Agar diffusion test is fast and inexpensive relative to other laboratory tests for antimicrobial activity. In addition, it requires media, reagents, equipment and supplies that are readily accessible to most clinical laboratories. Agar diffusion test is especially well suited for determining the ability of water-soluble antimicrobials to inhibit the growth of microorganisms. A number of samples can be screened for antimicrobial properties quickly using this test method.
Optical density, measured in a spectrophotometer, can be used as a measure of the concentration of bacteria in a suspension. As visible light passes through a cell suspension the light is scattered. Greater scatter indicates that more bacteria or other material is present. Using optical density is a fast way to obtain result compare to the agar diffusion test. In spectroscopy, the absorbance (also called optical density) of a material is a logarithmic ratio of the radiation falling upon a material, to the radiation transmitted through a material.
The spectrophotometric technique enables results to be available in 24 h, for various antimicrobial–microorganism combinations, easily and conveniently and with results that can be replicated. For every antimicrobial agent–microorganism association and for every antimicrobial concentration tested, the results obtained are not significantly different from those obtained with the viable count technique.REFERENCES
http://www.enotes.com/spectrophotometer-reference/spectrophotometer
http://en.wikipedia.org/wiki/Antimicrobial_agent